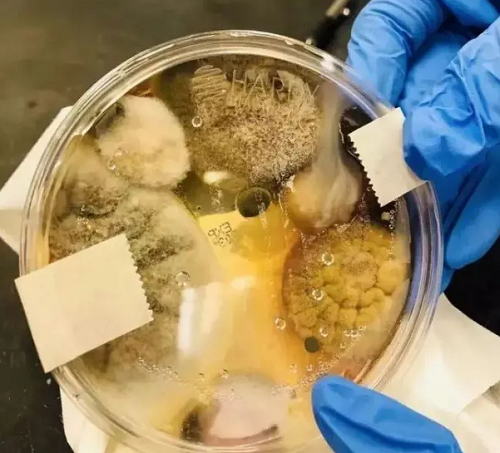
Để kiểm chứng độ bẩn của máy sấy khô, một sinh viên đại học tại Mỹ đã đặt đĩa petri (loại đĩa được làm bằng thủy tinh hoặc chất dẻo để nuôi cấy tế bào hay những cây rêu nhỏ) dưới máy sấy. Chỉ sau 3 phút, đĩa petri đựng lượng lớn vi khuẩn, với nhiều chủng khác nhau.

Người phụ nữ sau đó đã phải ôm con bỏ chạy để tránh chồng sau khi bị chồng đánh dã man mặc cho con nhỏ khóc thét giữa nhà gây bức xúc.





Diễn viên hài Lê Dương Bảo Lâm đăng tải loạt ảnh con trai thứ ba Phin cố gắng tỏ ra lạnh lùng.

Mook Karnruethai Tassabut ngày càng quyến rũ, sắc sảo sau khi đoạt danh hiệu Á hậu Miss Cosmo 2024.

Mẫu MPV cỡ nhỏ Nissan Gravite giá siêu rẻ mới vừa được hé lộ thêm nhiều chi tiết thiết kế trước khi chính thức ra mắt vào tháng 1/2026 tới đây.

Meta đang thử nghiệm tính phí người dùng khi chia sẻ đường link trên Facebook, chỉ miễn phí 2 link mỗi tháng nếu không đăng ký Meta Verified.

Mí Háng đang vào mùa hoa tớ dày nở rực. Sắc hồng khoe sắc trong sương lạnh cuối đông khiến bản làng Mù Cang Chải trở nên rực rỡ, cuốn hút du khách thập phương.

Trong bộ ảnh mới, Quỳnh Trương khiến người hâm mộ phải ngẩn ngơ bởi vẻ đẹp thanh khiết, thoát tục tựa như một nàng thơ bước ra từ tranh vẽ.

Chiếc ấm trà cổ được thiết kế hình con cừu khiến các chuyên gia sửng sốt vì độ tinh xảo. Vật dụng này thuộc về ai và vì sao tồn tại tới ngày nay?

Thông qua hoạt động đặt bẫy ảnh, Khu Bảo tồn thiên nhiên Pù Hoạt (tỉnh Nghệ An) lần đầu tiên ghi nhận sự xuất hiện của beo lửa đặc biệt quý hiếm.

Tại sự kiện, siêu mẫu Thanh Hằng được chồng giúp chỉnh sửa phục trang. Từ khi kết hôn, cả hai không ít lần sánh đôi trước công chúng.

New York mùa đông thu hút du khách bởi tuyết trắng phủ khắp đường phố, công viên và quảng trường, mở ra hành trình khám phá lãng mạn và giàu trải nghiệm.

Sau chiến thắng của U22 Việt Nam trước Thái Lan tại trận chung kết SEA Games vào tối qua, nhiều người dân đã rủ nhau tràn xuống đường, cùng ăn mừng đầy cảm xúc.

Sau gần một năm điều trị ung thư, diva Hồng Nhung xuất hiện với diện mạo rạng rỡ, tinh thần lạc quan và phong độ nghệ thuật bền bỉ.

Theo tử vi 12 cung hoàng đạo ngày 20/12, Xử Nữ có thể gặp quý nhân, thu nhập dễ tăng mạnh. Bọ Cạp thành công đừng quá tự mãn.

Nhiều mẫu đồng hồ Patek Philippe đạt mức giá hàng triệu USD trong các phiên đấu giá quốc tế.

Chuẩn bị đón Giáng sinh, vợ cũ Đan Trường chi khoảng 1.000 USD (khoảng 26 triệu đồng) mua cây thông trang trí căn biệt thự.

Trong khi thị trường quốc tế vẫn chờ thế hệ mới của Toyota Corolla, Trung Quốc lại được ưu ái với phiên bản nâng cấp 2026 đáng chú ý cho mẫu sedan cỡ C này.

Nữ ca sĩ Thủy Tiên gây chú ý khi đăng tải clip bên Công Vinh, hài hước cho biết rằng cô xài đồ không hao.

Ẩm thực Huế đứng thứ 36 trong danh sách Best Food Cities in the World 2025 của TasteAtlas, trở thành đại diện Việt Nam có thứ hạng cao nhất, gây chú ý quốc tế.

Quân đội Nga tiến hành không kích ồ ạt, khiến hoạt động sản xuất quốc phòng của Ukraine bị tê liệt; đồng thời gây tâm lý căng thẳng cho người dân Ukraine.

Nguyễn Thanh Nhàn, người hùng của U22 Việt Nam tại SEA Games 33 gây chú ý với chuyện tình yêu xa 1700km bên cạnh màn trình diễn xuất sắc.